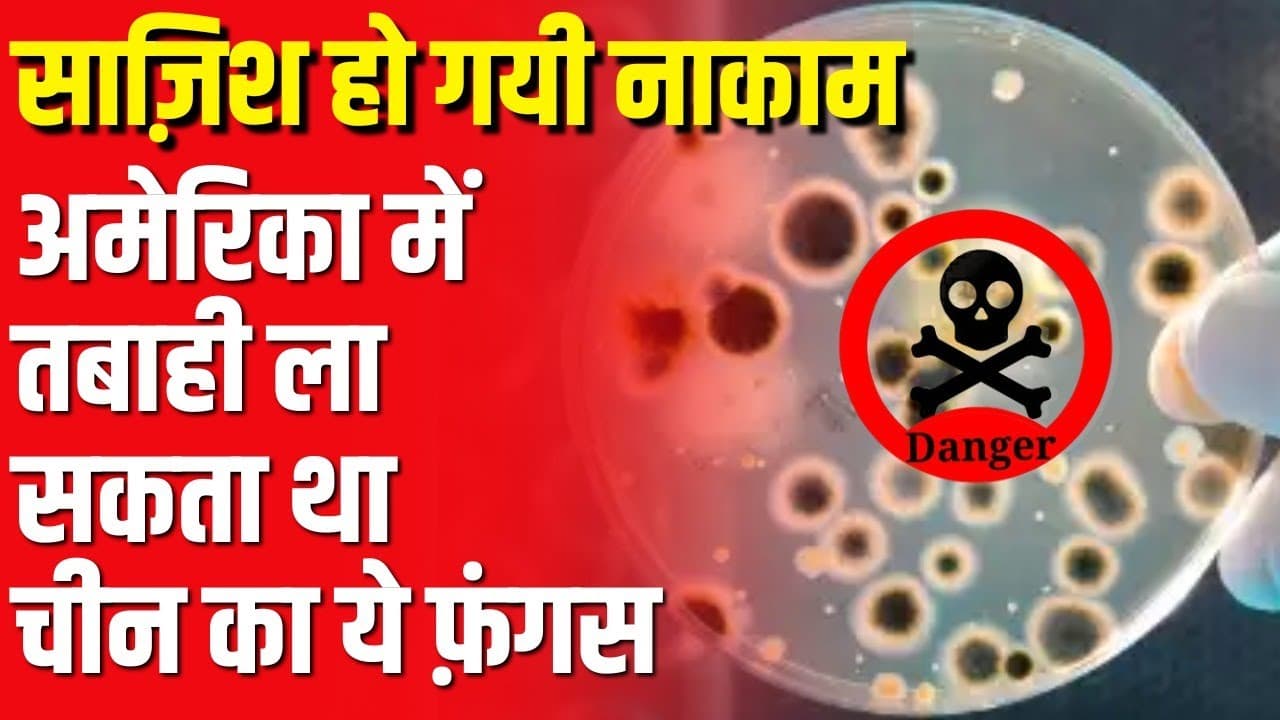

फिर विवाद में घिरे विजय शाह, रेप पीड़िता के परिवार की पहचान क्यों हुई उजागर?
- वीडियो
- |
- 4 Jun, 2025

मध्य प्रदेश के मंत्री विजय शाह खंडवा में बलात्कार-हत्या पीड़िता के परिवार से मुलाकात के बाद विवाद में। वायरल वीडियो से पीड़िता की पहचान उजागर, सुप्रीम कोर्ट गाइडलाइंस का उल्लंघन। पहले भी सोफिया कुरैशी पर टिप्पणी से चर्चा में। बीजेपी पर कार्रवाई न करने, कांग्रेस ने "लापता मंत्री" अभियान शुरू किया।

.jpg&w=3840&q=75)


















